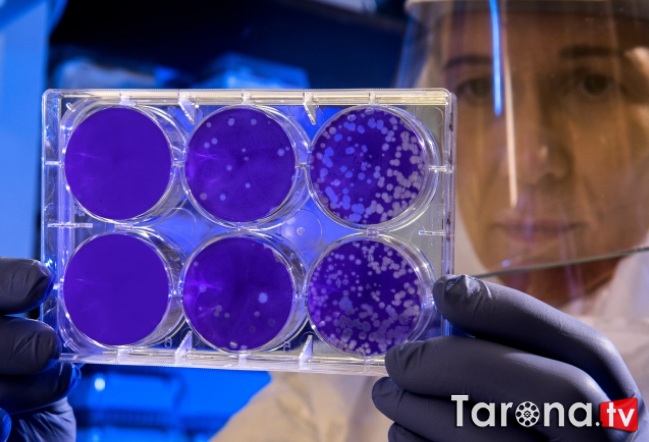

19:07 Yozda koronavirusning xavfli tashuvchisi paydo bo‘lishi mumkin | |
 Yoz fasliga kelib yangi turdagi COVID-19 koronavirusining yangi xavfli tashuvchisi paydo bo‘lishi mumkin, degan immunolog-allergolog, tibbiyot fanlari nomzodi Nadejda Logina. Sputnik Tojikiston xabari asosida. Shifokor so‘zlariga ko‘ra, agar koronavirus tarqalishi kelayotgan yoz fasliga qadar to‘xtamasa, terak momig‘i infeksiyalanish darajasini oshirishi mumkin ekan. "Agar iyun oyi o‘rtalariga, ya’ni terak gullashni boshlagan vaqtga kelib epidemiyani to‘xtata olmasak, vaziyat murakkab tus olishi mumkin. <...> Terak momig‘i koronavirusning faol tashuvchisiga aylanadi, men bu holatni hozirdan ko‘ra bilyapman", - dedi Logina.Allergologning aytishicha, terak gullagan mahalda odamlarda aksariyat hollarda nafas olish organlari allergik kasalliklari avj oladi. Shu bois, koronavirus tarqalishi vaqtida barcha allergiklar xatar zonasida bo‘lishi mumkin, dedi u. Shifokor prognoziga ko‘ra terak gullashi va kasallik kuchayishi mavsumi yaqin vaqtda boshlanishi mumkin. Loginaning ta’kidlashicha, har qanday turdagi allergik kasalliklardan aziyat chekuvchi odamlar mikrob va viruslarni yuqtirishga ko‘proq moyil bo‘ladi. "Bu birinchi galda bronxial astmaning turli shakllari, allergik rinitga chalingan va gullash mavsumi vaqtida kasallik kuchayishidan aziyat chekuvchi odamlardir - bunday odamlar Yer yuzida 20%dan ko‘p. <...> Ular barcha xavfsizlik choralariga qat’iy rioya etishlari shart", - deya tushuntiradi mutaxassis.Koronavirus pandemiyasiKoronavirus epidemiyasi 2019 yilning oxirida Xitoyda yuz bergan edi. Mart oyining o‘rtalariga yaqin BSST pandemiya haqida e’lon qildi. 16 aprel statistikasiga muvofiq Yer yuzida koronavirus infeksiyasiga chalinganlar soni 2 milliondan oshgan. Kasallik 210ta davlat va mustaqil hududlarda tarqalgan. Virus tufayli 135 mingga yaqin kishi qurbon bo‘lgan.
Manba: "aniq.uz"
| |
|
| |